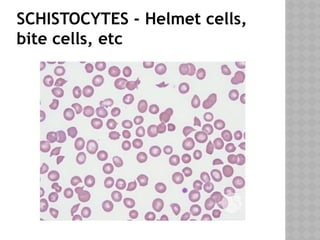
SCHISTOCYTES - Helmet cells,
bite cells, etc

RBC Membrane structure and its disorders. I am Dr. Samhati Tripathy from Department of Transfusion Medicine, S.C.B. Medical College, Odisha, India. Here, we will discuss structure of RBC membrane in detail with its receptors, their significance and the disorders arising out of it. Enzyme disorders are not included here.